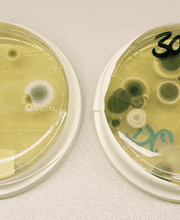
Labor Enders Bild 4

Bitte rufen Sie uns für genauere Informationen an!
Labor Enders
Labor
0.0(0 Bewertungen)
Rosenbergstraße 85, 70193 Stuttgart
+4971163570 (Telefon)
News & Angebote
Öffnungszeiten
- Montag
- 08:30 bis 15:30
- Dienstag
- 08:30 bis 15:30
- Mittwoch
- 08:30 bis 15:30
- Donnerstag
- 08:30 bis 15:30
- Freitag
- 08:30 bis 15:30
- Samstag
- Geschlossen
- Sonntag
- Geschlossen
Branchen / Spezialisierungen
LaborMedien

Map
Rosenbergstraße 85, 70193 Stuttgart
Bewertungen
Nicht verifizierte Bewertungen0.0
(0 Bewertungen)


